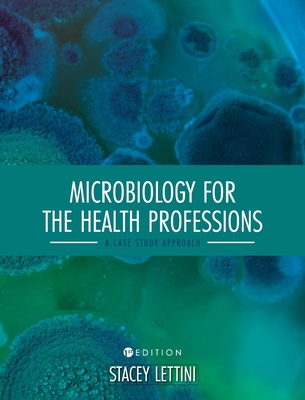

Microbiology for the Health Professions: A Case Study Approach
Microbiology for the Health Professions: A Case Study Approach
PRP: 2523.57 Lei
Acesta este Prețul Recomandat de Producător. Prețul de vânzare al produsului este afișat mai jos.
2271.21Lei
2271.21Lei
2523.57 LeiIndisponibil
Descrierea produsului
Detaliile produsului










